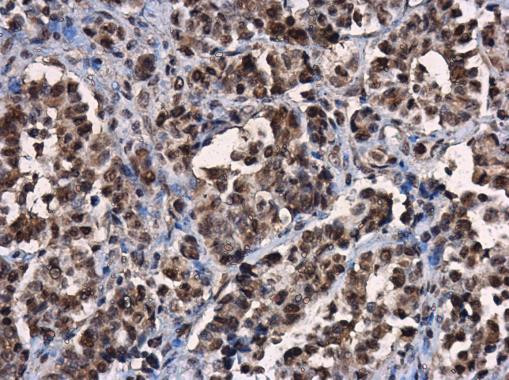
ERK2 Antibody in Immunohistochemistry (Paraffin) (IHC (P))

Search
Invitrogen
ERK2 Polyclonal Antibody
{{$productOrderCtrl.translations['antibody.pdp.commerceCard.promotion.promotions']}}
{{$productOrderCtrl.translations['antibody.pdp.commerceCard.promotion.viewpromo']}}
{{$productOrderCtrl.translations['antibody.pdp.commerceCard.promotion.promocode']}}: {{promo.promoCode}} {{promo.promoTitle}} {{promo.promoDescription}}. {{$productOrderCtrl.translations['antibody.pdp.commerceCard.promotion.learnmore']}}
产品信息
PA5-78132
种属反应
宿主/亚型
分类
类型
抗原
偶联物
形式
浓度
规格
纯化类型
保存液
内含物
保存条件
运输条件
RRID
产品详细信息
Positive Control: HeLa, 293T, A431, H1299, HeLaS3, HepG2, Molt-4, Raji, Mal19
Predicted Reactivity: Dog (100%), Pig (100%), Bovine (100%)
Store product as a concentrated solution. Centrifuge briefly prior to opening the vial.
靶标信息
MAPK1 (ERK2) is a serine/threonine kinase that acts as an important activator of p90 RSK, MSK, ELK1, and Stat3, and is involved in the MAPK pathway. MAP kinases, also known as extracellular signal-regulated kinases (ERKs), act as an integration point for multiple biochemical signals, and are involved in a wide variety of cellular processes such as proliferation, differentiation, transcription regulation and development. The activation of this kinase requires its phosphorylation by upstream kinases. Upon activation, this kinase translocates to the nucleus of the stimulated cells, where it phosphorylates nuclear targets.
⚠WARNING: This product can expose you to chemicals including mercury, which is known to the State of California to cause birth defects or other reproductive harm. For more information go to www.P65Warnings.ca.gov.
仅用于科研。不用于诊断过程。未经明确授权不得转售。
篇参考文献 (0)
生物信息学
蛋白别名: ERK-2; Erk2; cancer susceptibility protein; ERT1; Extracellular signal-regulated kinase 2; MAP kinase 1; MAP kinase 2; MAP kinase isoform p42; MAPK 2; Mitogen-activated protein kinase 1; Mitogen-activated protein kinase 2; p42-MAPK; protein tyrosine kinase ERK2; unnamed protein product
基因别名: ERK; ERK-2; ERK2; ERT1; MAPK1; MAPK2; NS13; p38; p40; p41; p41mapk; p42-MAPK; P42MAPK; PRKM1; PRKM2
UniProt ID: (Human) P28482
Entrez Gene ID: (Human) 5594, (Dog) 477575